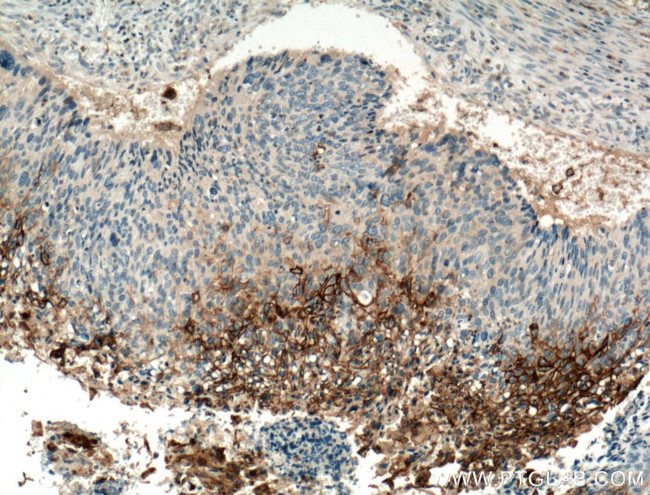
TGM1 Antibody in Immunohistochemistry (Paraffin) (IHC (P))

Search
Proteintech
TGM1 Polyclonal Antibody
{{$productOrderCtrl.translations['antibody.pdp.commerceCard.promotion.promotions']}}
{{$productOrderCtrl.translations['antibody.pdp.commerceCard.promotion.viewpromo']}}
{{$productOrderCtrl.translations['antibody.pdp.commerceCard.promotion.promocode']}}: {{promo.promoCode}} {{promo.promoTitle}} {{promo.promoDescription}}. {{$productOrderCtrl.translations['antibody.pdp.commerceCard.promotion.learnmore']}}
产品信息
12912-3-AP
种属反应
已发表种属
宿主/亚型
分类
类型
抗原
偶联物
形式
浓度
规格
纯化类型
保存液
内含物
保存条件
运输条件
产品详细信息
This antibody recognizes the endogenous 90 kDa TGM1 proteins.
Immunogen sequence: SGIFCCGPC SVESIKNGLV YMKYDTPFIF AEVNSDKVYW QRQDDGSFKI VYVEEKAIGT LIVTKAISSN MREDITYLYK HPEGSDAERK AVETAAAHGS KPNVYANRGS AEDVAMQVEA QDAVMGQDLM VSVMLINHSS SRRTVKLHLY LSVTFYTGVS GTIFKETKKE VELAPGASDR VTMPVAYKEY RPHLVDQGAM LLNVSGHVKE SGQVLAKQHT FRLRTPDLSL TLLGAAVVGQ ECEVQIVFKN PLPVTLTNVV FRLEGSGLQR PKILNVGDIG GNETVTLRQS FVPVRPGPRQ LIASLDSPQL SQVHGVIQVD VAPAPGDGGF FSDAGGDSHL GETIPMASRG GA (467-817 aa encoded by BC034699)
靶标信息
Protein kinase C (PKC) is a family of serine- and threonine-specific protein kinases that can be activated by calcium and second messenger diacylglycerol. PKC family members phosphorylate a wide variety of protein targets and are known to be involved in diverse cellular signaling pathways. PKC family members also serve as major receptors for phorbol esters, a class of tumor promoters. Each member of the PKC family has a specific expression profile and is believed to play a distinct role in cells.
仅用于科研。不用于诊断过程。未经明确授权不得转售。
生物信息学
蛋白别名: Epidermal TGase; K polypeptide; K polypeptide epidermal type I, protein-glutamine-gamma-glutamyltransferase; Protein-glutamine gamma-glutamyltransferase K; protein-glutamine-gamma-glutamyltransferase; TG K; TG(K); TGase 1; TGase K; TGase-1; TGK; transglutaminase 1 (K polypeptide epidermal type I, protein-glutamine-gamma-glutamyltransferase); transglutaminase 1, K polypeptide; Transglutaminase K; transglutaminase type 1; transglutaminase, keratinocyte; Transglutaminase-1; unnamed protein product
基因别名: 2310004J08Rik; ARCI1; ICR2; KTG; LI; LI1; TGASE; Tgase1; TGK; TGM1
UniProt ID: (Human) P22735, (Rat) P23606, (Mouse) Q9JLF6
Entrez Gene ID: (Human) 7051, (Rat) 60335, (Mouse) 21816